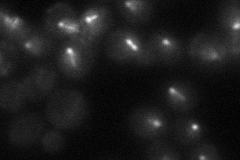
YKL052C
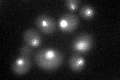
YKL052C

View description
Essential subunit of the Dam1 complex (aka DASH complex), couples kinetochores to the force produced by MT depolymerization thereby aiding in chromosome segregation; phosphorylated during the cell cycle by cyclin-dependent kinases
Localization:
Intensity:
Fold change:
Significance:
-
C’ GFP library in SD

punctate29.88 -
N' NOP1pr-GFP in SD

punctate,nucleus56.4739 -
N' TEF2pr-mCherry in SD

punctate,nucleus44.1365 -
N' NATIVEpr-GFP in SD
punctate31.668 -
N' TEF2pr-VC and Cyto-VN in SD

punctate27.3277 -
C’ GFP library in SD+DTT
punctate32.371.08No -
C’ GFP library in SD+H2O2

punctate32.321.08No -
C’ GFP library in Starvation Media

punctate30.421.01No -
C’ GFP library on the background of Pup2-DaMP

punctate -
C’ GFP library on the background of CCT mutant

punctate27.14480.908148No
